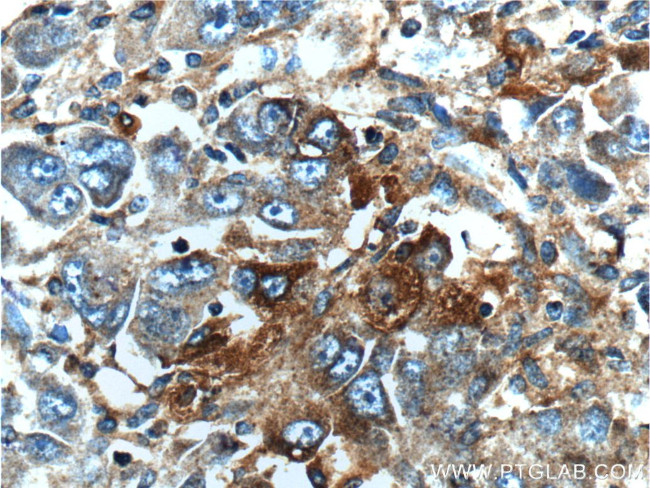
MAP3K6 Antibody in Immunohistochemistry (Paraffin) (IHC (P))
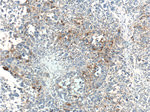
MAP3K6 Antibody in Immunohistochemistry (Paraffin) (IHC (P))
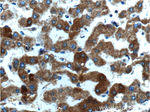
MAP3K6 Antibody in Immunohistochemistry (Paraffin) (IHC (P))

Search
Proteintech
MAP3K6 Polyclonal Antibody
{{$productOrderCtrl.translations['antibody.pdp.commerceCard.promotion.promotions']}}
{{$productOrderCtrl.translations['antibody.pdp.commerceCard.promotion.viewpromo']}}
{{$productOrderCtrl.translations['antibody.pdp.commerceCard.promotion.promocode']}}: {{promo.promoCode}} {{promo.promoTitle}} {{promo.promoDescription}}. {{$productOrderCtrl.translations['antibody.pdp.commerceCard.promotion.learnmore']}}
产品信息
16212-1-AP
种属反应
宿主/亚型
分类
类型
抗原
偶联物
形式
浓度
规格
纯化类型
保存液
内含物
保存条件
运输条件
产品详细信息
Immunogen sequence: MNLLLSYRD VQDYSAIIEL VETLQALPTC DVAEQHNVCF HYTFALNRRN RPGDRAKALS VLLPLVQLEG SVAPDLYCMC GRIYKDMFFS SGFQDAGHRE QAYHWYRKAF DVEPSLHSGI NAAVLLIAAG QHFEDSKELR LIGMKLGCLL ARKGCVEKMQ YYWDVGFYLG AQILANDPTQ VVLAAEQLYK LNAPIWYLVS VMETFLLYQH FRPTPEPPGG PPRRAHFWLH FLLQSCQPFK TACAQGDQCL VLVLEMNKVL LPAKLEVRGT DPVSTVTLSL LEPETQDIPS SWTFPVASIC GVSASKRD (1-307 aa encoded by BC015914)
靶标信息
Mitogen-activated protein kinase (MAPK) signaling cascades include MAPK or extracellular signal-regulated kinase (ERK), MAPK kinase (MKK or MEK), and MAPK kinase kinase (MAPKKK or MEKK). MAPKK kinase/MEKK phosphorylates and activates its downstream protein kinase, MAPK kinase/MEK, which in turn activates MAPK. The kinases of these signaling cascades are highly conserved, and homologs exist in yeast, Drosophila, and mammalian cells. MEKK6 activates the JNK, but not ERK or p38 kinase pathways.
仅用于科研。不用于诊断过程。未经明确授权不得转售。
篇参考文献 (0)
生物信息学
蛋白别名: Apoptosis signal-regulating kinase 2; map3k6; MAPKKK6; MGC125653; MGC20114; mitogen activated protein kinase kinase kinase 6; Mitogen-activated protein kinase kinase kinase 6; OTTHUMP00000005063
基因别名: ASK2; MAP3K6; MAPKKK6; MEKK6
UniProt ID: (Human) O95382
Entrez Gene ID: (Human) 9064, (Mouse) 53608, (Rat) 313022